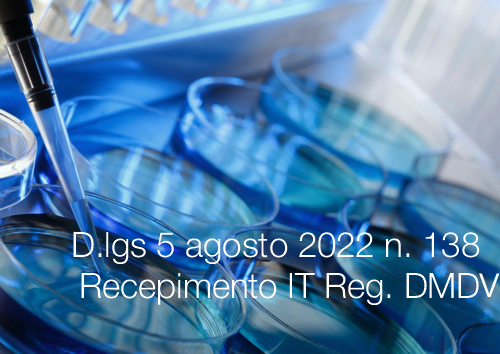
Decreto Legislativo 5 agosto 2022 n 138 DMDV Decreto Legislativo 5 agosto 2022 n 138 DMDV

Decreto Legislativo 5 agosto 2022 n. 138
| ID 17584 | | Visite: 4732 | Regolamento DMD Vitro | Permalink: https://www.certifico.com/id/17584 |
Decreto Legislativo 5 agosto 2022 n. 138 / Recepimento IT Reg. Dispositivi Medico-Diagnostici in Vitro (DMDV)
ID 17584 | 13.09.2022
Decreto Legislativo 5 agosto 2022 n. 138
Disposizioni per l'adeguamento della normativa nazionale alle disposizioni del regolamento (UE) 2017/746, relativo ai dispositivi medico-diagnostici in vitro e che abroga la direttiva 98/79/CE e la decisione 2010/227/UE della commissione, nonche' per l'adeguamento alle disposizioni del regolamento (UE) 2022/112 che modifica il regolamento (UE) 2017/746 per quanto riguarda le disposizioni transitorie per determinati dispositivi medico-diagnostici in vitro e l'applicazione differita delle condizioni concernenti i dispositivi fabbricati internamente ai sensi dell'articolo 15 della legge 22 aprile 2021, n. 53.
(GU n.214 del 13.09.2022)
Entrata in vigore del provvedimento: 28/09/2022
- Salvo quanto stabilito nei commi 2, 3, 4, 5, 6 e 7, il decreto legislativo 8 settembre 2000, n. 332, è abrogato dal 28.09.2022. (*) Articolo 34 co. 3 Funzionalità di Eudamed regolamento (UE) 2017/745
- L’articolo 11 del decreto legislativo n. 332 del 2000, è abrogato decorsi sei mesi dalla data di pubblicazione dell’avviso di cui all’articolo 34, paragrafo 3, del regolamento (UE) n. 2017/745 (*).
- L’articolo 10 del decreto legislativo n. 332 del 2000, è abrogato decorsi ventiquattro mesi dalla data di pubblicazione dell’avviso di cui all’articolo 34, paragrafo 3, del regolamento (UE) n. 2017/745 (*).
- L’articolo 12, comma 1, lettere a) e b) del decreto legislativo n. 332 del 2000, è abrogato decorsi ventiquattro mesi dalla data di pubblicazione dell’avviso di cui all’articolo 34, paragrafo 3, del regolamento (UE) n. 2017/745 (*).
- L’articolo 12, comma 1, lettera c) , del decreto legislativo n. 332 del 2000, è abrogato decorsi sei mesi dalla data di pubblicazione dell’avviso di cui all’articolo 34, paragrafo 3, del regolamento (UE) n. 2017/745 (*).
- L’articolo 8, commi 7 e 8 e l’articolo 9, comma 9, del decreto legislativo n. 332 del 2000, sono abrogati decorsi ventiquattro mesi dalla data di pubblicazione dell’avviso di cui all’articolo 34, paragrafo 3, del regolamento (UE) n. 2017/745 (*).
- Le disposizioni del decreto legislativo n. 332 del 2000, relative ai dispositivi di cui all’articolo 110, paragrafi 3 e 4 del regolamento, restano in vigore fino alle date in esso indicate, nella misura necessaria dell’applicazione di tali paragrafi.
3. La Commissione, dopo aver consultato l'MDCG e aver appurato che le condizioni di cui al paragrafo 2 sono state soddisfatte, pubblica un avviso a tal fine nella Gazzetta ufficiale dell'Unione europea.
...
Articolato
Art. 1. Oggetto, finalità e ambito di applicazione
1. Il presente decreto legislativo detta le disposizioni necessarie all’adeguamento del quadro normativo nazionale al regolamento (UE) n. 2017/746 del Parlamento europeo e del Consiglio, del 5 aprile 2017, di seguito denominato: «regolamento», nonché le disposizioni necessarie all’attuazione dell’articolo 15 della legge 22 aprile 2021, n. 53.
Art. 2. Definizioni
Art. 3. Autorità competente e Autorità responsabile degli organismi notificati
Art. 4. Messa a disposizione sul mercato, messa in servizio e obblighi degli operatori economici
Art. 5. Requisiti generali di sicurezza e prestazioni
Art. 6. Libera circolazione e dispositivi per destinazioni particolari
Art. 7. Organismi notificati
Art. 8. Valutazione della conformità e autorizzazioni in deroga
Art. 9. Registrazione degli operatori economici nel sistema elettronico Eudamed
Art. 10. Banca dati europea dei dispositivi medici Eudamed
Art. 11. Banca dati nazionale
Art. 12. Identificazione, tracciabilità e nomenclatura dei dispositivi
Art. 13. Procedure di vigilanza
Art. 14. Studi delle prestazioni
Art. 15. Sorveglianza del mercato
Art. 16. Classificazione dei dispositivi medico-diagnostici in vitro e criteri di soluzione delle controversie
Art. 17. Marcatura CE di conformità
Art. 18. Valutazione delle tecnologie sanitarie
Art. 19. Commercio dei dispositivi
Art. 20. Offerta in vendita a distanza dei dispositivi medicodiagnostici in vitro
Art. 21. Dispositivi falsificati
Art. 22. Pubblicità
Art. 23. Provvedimenti di diniego o di restrizione
Art. 24. Fondo per il governo dei dispositivi medici
Art. 25. Definizione dei tetti di spesa
Art. 26. Riservatezza
Art. 27. Sanzioni
Art. 28. Disposizioni tariffarie
Art. 29. Disposizioni transitorie e finali
1. Per i dispositivi di cui all’articolo 110, paragrafi 3 e 4 del regolamento continua ad applicarsi la normativa nazionale nella misura necessaria all’applicazione di tali disposizioni, fino alle date in esso indicate.
2. Per i dispositivi immessi in commercio ai sensi dell’articolo 110 del regolamento con un certificato emesso ai sensi della direttiva n. 98/79/CE, l’organismo notificato che lo ha rilasciato continua ad essere responsabile dell’appropriata sorveglianza di tutti i requisiti applicabili relativi al dispositivo che ha certificato, ed è soggetto alla sorveglianza da parte del Ministero della salute.
3. Fino alla pubblicazione dell’avviso di cui all’articolo 34, paragrafo 3, del regolamento (UE) n. 2017/745, per i dispositivi immessi sul mercato ai sensi degli articoli 5 e 110, paragrafo 3, del regolamento, si applicano le disposizioni di cui all’articolo 8, commi 7 e 8 e all’articolo 9, comma 9, del decreto legislativo 8 settembre 2000, n. 332; continuano ad applicarsi, inoltre, le disposizioni contenute nel decreto applicativo di cui all’articolo 10 del decreto legislativo 8 settembre 2000, n. 332, nonché le procedure nazionali implementate nell’ambito del Nuovo sistema informativo sanitario per la notifica delle informazioni relative alla vigilanza e agli studi delle prestazioni di cui agli articoli 13 e 14 del presente decreto.
4. Dalla data di pubblicazione dell’avviso di cui all’articolo 34, paragrafo 3, del regolamento (UE) n. 2017/745 e fino alle date di abrogazione di cui al successivo articolo 30, commi 2, 3, 4, 5 e 6 al fine di ottemperare agli obblighi previsti dalle disposizioni del regolamento per quanto riguarda lo scambio di informazioni tra cui, in particolare, quelle riguardanti gli studi delle prestazioni, i rapporti di vigilanza, le registrazioni di dispositivi e operatori economici, nonché le notifiche di certificazione è consentito l’impiego delle modalità di comunicazione dettate dalle disposizioni di cui al comma 3.
5. Per quanto non previsto dal presente articolo, si applicano le disposizioni di cui all’articolo 110 del regolamento.
Art. 30. Abrogazioni
1. Salvo quanto stabilito nei commi 2, 3, 4, 5, 6 e 7, il decreto legislativo 8 settembre 2000, n. 332, è abrogato dalla data di entrata in vigore del presente decreto.
2. L’articolo 11 del decreto legislativo n. 332 del 2000, è abrogato decorsi sei mesi dalla data di pubblicazione dell’avviso di cui all’articolo 34, paragrafo 3, del regolamento (UE) n. 2017/745.
3. L’articolo 10 del decreto legislativo n. 332 del 2000, è abrogato decorsi ventiquattro mesi dalla data di pubblicazione dell’avviso di cui all’articolo 34, paragrafo 3, del regolamento (UE) n. 2017/745.
4. L’articolo 12, comma 1, lettere a) e b) del decreto legislativo n. 332 del 2000, è abrogato decorsi ventiquattro mesi dalla data di pubblicazione dell’avviso di cui all’articolo 34, paragrafo 3, del regolamento (UE) n. 2017/745.
5. L’articolo 12, comma 1, lettera c) , del decreto legislativo n. 332 del 2000, è abrogato decorsi sei mesi dalla data di pubblicazione dell’avviso di cui all’articolo 34, paragrafo 3, del regolamento (UE) n. 2017/745.
6. L’articolo 8, commi 7 e 8 e l’articolo 9, comma 9, del decreto legislativo n. 332 del 2000, sono abrogati decorsi ventiquattro mesi dalla data di pubblicazione dell’avviso di cui all’articolo 34, paragrafo 3, del regolamento (UE) n. 2017/745.
7. Le disposizioni del decreto legislativo n. 332 del 2000, relative ai dispositivi di cui all’articolo 110, paragrafi 3 e 4 del regolamento, restano in vigore fino alle date in esso indicate, nella misura necessaria dell’applicazione di tali paragrafi.
Art. 31. Clausola di invarianza finanziaria
...
Collegati
Schema Dlgs adeguamento regolamento (UE) 2017/746 - Dispositivi medico-diagnostici in vitro
Regolamento (UE) 2017/746
Norme armonizzate Regolamento dispositivi medici-diagnostici in vitro 2017/746/UE